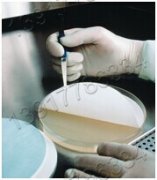

美國Merck Millipore默克密理博生命科學(xué)產(chǎn)品系列(九)
美國Merck Millipore默克密理博生命科學(xué)產(chǎn)品系列(九)
產(chǎn)品簡述:Millipore 生命科學(xué)產(chǎn)品大全

| 美國Merck Millipore默克密理博生命科學(xué)產(chǎn)品系列(九) | |
| 產(chǎn)品貨號 | 產(chǎn)品描述 |
| Item Number | Item Description |
| XF2004710 | SS FILTER HOLDER 100ML 47MM |
| XF2004725 | SS FILTER HOLDER 250ML 47MM |
| XF2004752 | SS BASE FOR 47MM SS FILTER HOLDER |
| XF2004755 | SS FUNNEL 100ML 47MM |
| XF2004756 | SS FUNNEL 250ML 47MM |
| XF2004758 | SS SUPPORT FRIT FOR 47MM SS FILTER HOLDR |
| XF2004763 | FUNNEL COVER 250/300 ML |
| XF3001200 | SS EPIFLUORESCENCE FILTER HOLDER, 13MM |
| XF5423050 | Millivac Mini Vacuum Pump, 230v 50Hz |
| XF5423055 | EPDM MEMBRANE KIT FOR MILLIVAC MINI PUMP |
| XF5423056 | PTFE MEMBRANE KIT FOR MILLIVAC MINI PUMP |
| XKEM00104 | 2-WAY PLASTIC VACUUM VALVE 1/PK |
| XKEM00107 | HAND VACUUM PUMP PP |
| XT1200000 | PTFE TUBING FOR SOLVENT/BUFFER 70CM |
| XX1002500 | GLASS FILTER HOLDER, 25MM, FRIT SUPPORT |
| XX1002502 | FRITTED GLASS BASE W/STOPPER, 25MM |
| XX1002503 | SPRING CLAMP F/25MM GLASS FILTER HOLDER |
| XX1002505 | FILTER FLASK 125ML |
| XX1002508 | STOPPER 5/PK SIZE 5 |
| XX1002514 | 15ML GLASS FUNNEL, 25MM |
| XX1002530 | GLASS FILTER HOLDER, 25MM, SS SUPPORT |
| XX1002532 | GLASS BASE W/STOPPER AND SS SCREEN, 25MM |
| XX1002535 | PTFE GASKET FOR GLASS HLDR 25MM, 10/PK |
| XX1002540 | ANALYTICAL 50ML SS FILTER HOLDER, 25MM |
| XX1002542 | BASE FOR 25MM SS FILTER HOLDER W/SS SCR |
| XX1004700 | GLASS FILTER HLDR 47MM 300ML FUNNEL |
| XX1004702 | FRITTED BASE FOR 47MM GLASS FILTER HOLDR |
| XX1004703 | SPRING CLAMP FOR 47MM GLASS FILTER HOLDR |
| XX1004704 | 300ML GLASS FUNNEL, 47MM |
| XX1004705 | VACUUM FILTERING FLASK, 1L |
| XX1004707 | 1L FUNNEL, 47MM, GROUND GLASS SEAL |
| XX1004708 | SILICONE NO 8 STOPPER 9/16 HOLE, 5/PK |
| XX1004710 | Flow reducing washer 25mm whole 300/Pk |
| XX1004720 | GLSS HLDER 47MM PTFE COATED 300ML FUNNEL |
| XX1004722 | PTFE-FACED GLASS BASE, 47MM |
| XX1004724 | PTFE-FACED GLASS FUNNEL, 300ML |
| XX1004730 | GLASS HOLDER 47MM SS SCREEN 300ML FUNNEL |
| XX1004732 | GLASS BASE W/STOPPER AND SS SCREEN, 47MM |
| XX1004733 | GLASS BSE AND STOPPR W/O SS SCREEN 47MM |
| XX1004744 | VACUUM FILTERING FLASK, 4L |
| XX10047KT | Filtration Kit for Progress Energyl |
| XX1007615 | MICROSCOPE SLIDES 2"X3" 72/PK |
| XX1009000 | 1L FUNNEL, 90MM, GROUND GLASS SEAL |
| XX1009002 | 90MM SS PTFE COATED SCREEN |
| XX1009003 | SPRING CLAMP F/90MM GLASS FILTER HOLDER |
| XX1009004 | VACUUM BASE AND CAP, 90MM |
| XX1009010 | 90MM PTFE GASKET, 10/PK |
| XX1009011 | 90MM GRND GLASS GL BASE W/ |
| XX1009020 | GLASS FILTER HOLDER W/SS SCREEN, 90MM |
| XX1100000 | 600ML BENCH-TOP PRESSURE RESERVOIR |
| XX1100001 | BALL VALVE, 1/4 NPT |
| XX1100002 | O-RING SILICON 2-137 6/PK |
| XX11000PP | BALL VALVE 1/4" HOSE |
| XX1102503 | M-M LUER ADAPTOR NYLON 4PK |
| XX1104700 | PLASTIC FILTER HOLDER 47MM STERIFIL |
| XX1104702 | STERIFIL BASE AND SUPPORT SCREEN |
| XX1104703 | STERIFIL FUNNEL COVER |
| XX1104704 | STERIFIL FUNNEL, 250ML, 47MM |
| XX1104705 | STERIFIL RECEIVER FLASK, 250ML |
| XX1104706 | STERIFIL RECEIVER FLASK COVER |
| XX1104707 | SILICONE O-RING 5-329 10/pk |
| XX1104710 | STERIFIL HOLDER 47MM W/O RECEIVER FLASK |
| XX1104711 | STERIFIL GUM RUBBER CAPS 100/PK |
| XX1104715 | 47MM SUPPORT SCREEN |
| XX11J4750 | STERIFIL HOLDER 47MM, 500ML |
| XX1504700 | ALL-GLSS FILTR HLDR COMPLETE 47MM FUNNEL |
| XX1504702 | VACUUM GLASS BASE AND CAP, 47MM |
| XX1504705 | GROUND JOINT FLASK, 1L |
| XX1504732 | VACUUM GLASS BASE, CAP W/SS SCREEN, 47MM |
| XX1604700 | MILLISOLVE SOLVENT CLARIFICATION KIT 2L |
| XX1604701 | VACUUM COVER, GROUND GLASS |
| XX1604705 | 2L VACUUM FLASK W/CONICAL BOTTOM |
| XX1604706 | 5L VACUUM FLASK W/CONICAL BOTTOM |
| XX2004701 | FUNNEL LOCKING RING 1/PK |
| XX2004702 | HYDROSOL SS BASE W/SCREEN GASKET STOPPER |
| XX2004703 | PTFE GASKET FOR HYDROSOL, 25/PK |
| XX2004704 | HYDROSOL SS FUNNEL AND LOCKING RING |
| XX2004707 | LOCKWHEELS (2) AND WRENCH SET |
| XX2004708 | SS SUPPORT SCREEN, 47MM |
| XX2004718 | SILICONE NO 8 STOPPER 3/8 HOLE, 5/PK |
| XX2004720 | HYDROSOL SS 47MM FILTER HOLDER |
| XX20047RK | HYDROSOL REPLACEMENT PARTS KIT |
| XX2702509 | FILTER O-RING SILICONE, 30/PK |
| XX2702510 | PP SUPPORT SCREEN 25MM, 30/PK |
| XX2702512 | 2-WAY SST INLET VALVE 1/8"NPTM |
| XX2702550 | 1225 SAMPLING MANIFOLD |
| XX2702552 | 1225 MANIFOLD CHAMBERS O-RINGS&PLUG SET |
| XX2702555 | 1225 MANIFOLD SMPLE CUP EXTENSION BARREL |
| XX3001200 | SWINNY SS FILTER HOLDER, 13MM |
| XX3001202 | SUPPORT SCRN PTFE GASKT 10/PK |
| XX3001210 | SS PHOTOETCHED SCREEN |
| XX3001240 | ANALYTICAL SS FILTER HOLDER, 13MM |
| XX30012RK | SWINNY 13MM REPLACEMENT PARTS KIT |
| XX3002500 | MICROSYRINGE SS FILTER HOLDER, 25MM |
| XX3002502 | PTFE GASKET 10/PK |
| XX3002510 | SS SUPPORT SCREEN FOR 25MM MICROSYRINGE |
| XX3002514 | MICROSYRINGE SS FILTER HOLDER, 25MM |
| XX3002561 | 1/8NPTM TO MAL LUER CHROM/NICK |
| XX3002564 | 1/4ID HOSE-MALE LUER NICKLE PLATED BRASS |
| XX3002567 | 1/8 NPTF TO M-LUER NICKEL plated |
| XX3002568 | 1/4" NPTF to F-luer 316SS |
| XX3002570 | 1/4 NPTM TO M-LUER LOCK NICKLE PLAT |
| XX30025RK | MICROSYRINGE 25MM REPLACEMENT PARTS KIT |
| XX4002500 | GAS IN-LINE SS FILTER HOLDER, 25MM |
| XX4002516 | O-RING FLUOROELASTOMER 2-021 6/PK |
| XX40025RK | REPLACEMENT PARTS KIT FOR FILTERJET FILT |
| XX40025SL | DUALEX GASLINE HOLDER |
| XX4004700 | SS PRESSURE FILTER HOLDER 47MM, 100ML |
| XX4004704 | SS FILTER SUPPORT SCREEN, 47MM FOR SS PR |
| XX4004714 | LOCKING RING GASKET, PTFE, 5/PK |
| XX4004716 | PTFE ORING 2-223 FOR SS PRESSURE FI |
| XX4004740 | SS PRESSURE FILTER HOLDER 47MM, 340ML |
| XX40047RK | REPLACEMENT PARTS KIT F/47MM SS PRESSURE |
| XX4204708 | VENT/RELIEF VALVE SS 275 PSI |
| XX4204709 | STIRRED CELL SUPPORT SCRN 47MM |
| XX42CF00T | CHIBITAN-II MICROCENTRIFUGE 1P |
| XX42CF0RT | CHIBITAN-R MICR0 CENTRIFUGE 1PK |
| XX4304700 | IN-LINE PP FILTER HOLDER, 47MM |
| XX4304701 | O-RING SILICONE 2-131 6/PK |
| XX4304702 | O-RING FLUOROELASTOMER 2-131 6/PK |
| XX4304704 | PP HOSE ADAPTER, 1/4" NPTM TO 5/16" |
| XX4304705 | HAND KNOBS FOR 47MM IN-LINE PP FILTE |
| XX4304707 | SS Support Screen for 47mm PP Filter |
| XX4404700 | SS FILTER HOLDER, 47MM |
| XX4404702 | SS PTFE-COATED SUPPORT SCREEN, 47MM |
| XX4404703 | SS BACK-PRESSURE SCREEN, 47MM |
| XX4502500 | HIGH-PRESSURE SS FILTER HOLDER, 25MM |
| XX4502504 | SS HIGH-PRESSURE SUPPORT SCREEN, 25MM |
| XX45025RK | REPLACEMENT PARTS KIT FOR HIGH PRESSURE |
| XX4504700 | HIGH-PRESSURE SS FILTER HOLDER, 47MM |
| XX4504704 | SS HIGH-PRESSURE SUPPORT SCREEN, 47MM |
| XX4504705 | PTFE-TREATED FLUOROELASTOMER INNER O-RIN |
| XX4504710 | PTFE INNER O-RING FOR HIGH PRESSURE SS F |
| XX4504713 | FLUOROELASTOMER OUTER O-RING FOR HIGH PR |
| XX45047RK | REPLACEMENT PARTS KIT FOR HIGH PRESSURE |
| XX5000000 | FFLOW-LIMITING ORIFICES, SET OF 5 |
| XX5000002 | FLOW-LIMITING ORIFICES, 1L/MIN |
| XX5000020 | FLOW-LIMITING ORIFICES, 2L/MIN |
| XX5002501 | SS SUPPORT SCREEN, 25MM |
| XX5004700 | SS AEROSOL STANDARD FILTER HOLDER, 47MM |
| XX5004710 | SS AEROSOL OPEN FILTER HOLDER, 47MM |
| XX5004740 | HOLDER 47MM SST GARMENT |
| XX5411560 | Millivac Mini Vacuum Pump, 115V, 60Hz |
| XX550002J | SERVICE KIT FOR XX5510000 |
| XX6200004 | SS AEROSOL ADAPTER, LUER SLIP TO 1/4.. |
| XX6200005 | ADAPTER TUBING TO MALE LUER F/AEROSOL AN |
| XX6200006 | SS FILTER FORCEPS, BLUNT END |
| XX6200006P | Forceps, blunt end, stainless steel 3pk |
| XX6200035 | HAND VACUUM PUMP SS |
| XX6200036 | REPLACEMENT PARTS KIT F/HAND VACUUM PUMP |
| XX6210000 | BABCOCK+WILCOX COLOR STANDARDS |
| XX6300120 | FILTER HOLDER ASSEMBLY |
| XX6403705 | REMOTE SAMPLING ASSY TUBE/ADP |
| XX6403708 | SAMPLER/VALVE/HOSE ASSEMBLY |
| XX6403714 | PIPE THREAD VALVE 1/8" - 1/8" NPTM |
| XX6403715 | AVIA. FUEL REDUCING ADAPTER |
| XX6403730 | FLUID SAMPLING KIT |
| XX6403735 | HOSE CONNECTOR 1/8" NPTF QUICK RELE |
| XX6403780 | TYGON TUBING 3/16" ID |
| XX6504700 | NAVAL PATCH TEST KIT |
| XX6504704 | WAXH BOT 500ML W/HOLE MOD. |
| XX6504707 | SWINNEX 25MM W/SCREEN |
| XX6504708 | HOLDER SUPPORT W/BASE SST |
| XX6504709 | PVC BOTTLE 120 ml 1/PK |
| XX6504710 | FLUOROELASTOMER TUBE W/NYLON ADAPT+CLAMP |
| XX6504711P | NAVY KIT PLACARD |
| XX6504712 | PATCH TEST KIT SPARE PARTS |
| XX6504713 | NAVAL HYDRAULIC COLOR GUIDE |
| XX6504730 | INDUSTRIAL PATCH TEST KIT |
| XX6504750 | Turbine Oil Test Kit, 115V |
| XX6504760 | Turbine Oil Assessement Kit for Europe |
| XX6504850 | Turbine Oil Test Kit, 220V |
| XX6602500 | SOLVENT FILTERING DISPENSER 25MM |
| XX6602501 | FILTERING FLASK AND NEOPRENE STOPPER |
| XX6700010 | ZHE cylinder o-ring FLUOROELASTOMER 3/pk |
| XX6700018 | PIPE THREAD CONNECTION ADAPTER |
| XX6700024 | VENT/RELIEF VALVE, 9 BAR |
| XX6700028 | HOSE CONNECTOR 1/4" NPTF QUICK RELE |
| XX6700030 | QUICK RELEASE NIPPLE AND COUPLING, 1/4" |
| XX6700034 | PVC TUBING, 3/8" ID 10FT W/CLAMPS 125PSI |
| XX6700035 | PVC TUBING, 1/2" ID 10FT W/CLAMPS 125PSI |
| XX6700037 | MEDICAL GRADE TUBING 1/4"ID, 1/2"OD 10FT |
| XX6700038 | MEDICL GRADE TUBING 1/2"ID 3/4"OD 10FT |
| XX6700059 | O-RING FLUOROELASTOMER A 5-381 |
| XX67000PK | PRESSURE VESSEL FITTING KIT |
| XX6700101 | PIPE THREAD FITTING 1/4" NPTF TEEE |
| XX6700104 | STREET ELBOW, 1/4" NPTF TO MALE |
| XX6700115 | 1/4" NPTM SS CLOSE NIPPLE |
| XX6700118 | ADAPTER 1/4" NPTF TO 1/4" ID HOSE NYON |
| XX6700125 | HEX NIPPLE, 1/4" NPTM 51MM, SS |
| XX6700133 | CLAMP (HOSE) 1/2" 4/PK |
| XX6700L11 | ADAPTR 1/4"NPTM -1/4",1/2"ID STEP, 2/PK |
| XX6700L15 | PRESSURE GAUGE, 1/4" ASME |
| XX6700L24 | VENT/RELIEF VALVE, 7 BAR, ASME |
| XX6700L55 | BUBBLE POINT TEST ASSY ASME |
| XX6700P00 | TCLP/ZHE Pressure Vessel Fittings Kit |
| XX6700P01 | PRESSURE VESSEL 316SS 1 GAL |
| XX6700P01FRW | 1L Presssure Vessel Shipping Kit for FRW |
| XX6700P05 | PRESSURE VESSEL 316SS 5L |
| XX6700P05FRW | 5L Presssure Vessel Shipping Kit for FRW |
| XX6700P10 | PRESSURE VESSEL 316SS 10L |
| XX6700P10FRW | 10L Presssure Vessel Shipping Kit f/FRW |
| XX6700P20 | PRESSURE VESSEL 316SS 20L |
| XX6700P20FRW | 20L Presssure Vessel Shipping Kit f/ FRW |
| XX6702500 | FILTERJET SOLVENT DISPENSER 25MM |
| XX6702501 | FILTERJET HANDLE + VALVE ASSEMBLY |
| XX6702502 | FILTERJET VALVE SEALS, PTFE 4/PK |
| XX6702506 | TUBE ADAPTER PE 1/4" NPTM TO 1/4" TUBE |
| XX6702507 | TUBE ADAPTER SS 1/4" NPTM TO 1/4" TUBE |
| XX6702508 | PP TUBING 6MM (0.25") OD x 3M |
| XX67025RK | REPLACEMENT PARTS KIT W/SS JET NOZZLE,FA |
| XX7100004 | SILICONE TUBING 3/16"ID x 140CM AUTOCLAV |
| XX7104712 | FLUID CONTAM ANAL KIT 230V50HZ |
| XX71J470J | STERIFIL-500 3 PLATE KIT |
| XX8020EL0 | FIXED SPEED PERISTALTIC PUMP (115V/60HZ) |
| XX8023EL0 | FIXED SPEED PERISTALTIC PUMP (230V/50HZ) |
| XXKT00P1J | TANK KIT 10L |
| XXKT00P2J | TANK KIT 20L |
| XXKT00P5J | TANK KIT 5L |
| XXKT013VJ | FLT KIT 13mm FOR PARTICULATE ANALYSIS |
| XXKT013VS | FLT KIT 13MM FOR PARTICULATE ANALYSIS. |
| XXKT0251J | RINSING KIT 10L |
| XXKT0252J | RINSING KIT 20L |
| XXKT0255J | RINSING KIT 5L |
| XXKT025VGJ | FLT KIT 25mm FOR SMALL QUANTITY ANALYSIS |
| XXKT025VJ | FLT KIT 25MM FOR PARTICULATE ANALYSIS |
| XXKT03P1J | MICROBIAL ANALYSIS (3PLACE+10L) |
| XXKT04700 | PRESSURE FILT KIT 600ML W/47MM |
| XXKT0471J | VACUUM FILT KIT |
| XXKT0472J | VACUUM FILTERING KIT SS HOLDER |
| XXKT0472SJ | SS MEASUREMENT KIT W/SS HOLDER |
| XXKT0473J | VACUUM FILT KIT 3-WAY MANIFOLD |
| XXKT047SJ | SS MEASUREMENT KIT WITH PYREX |
| XXKT06P20 | MICROBIAL ANALYSIS (6PLACE+20L) |
| XXKT09001 | PRESSURE FILT KIT 10L W/90MM |
| XXKT14201 | PRESSURE FILT KIT 20L W/142MM |
| XXKT29301 | VACUUM FLT KIT |
| XXKT293P1 | PRESSURE FILT KIT PUMP W/293MM |



